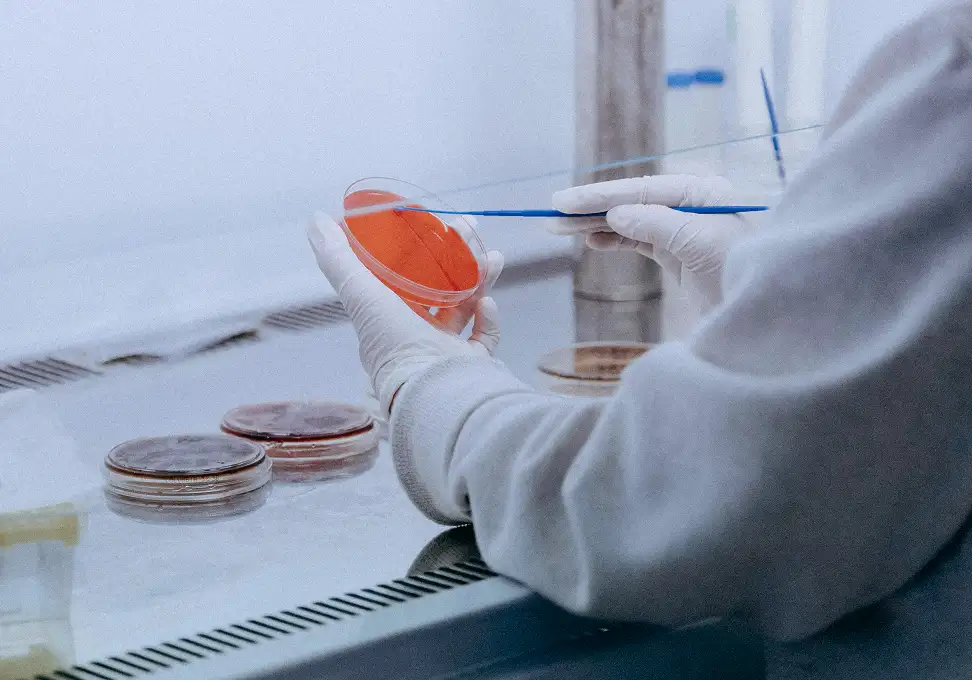

Where the World’s Best Science
Becomes Medicine
A scalable hub-and-spoke engine for global drug development
Our Approach
K2 Therapeutics is a biotech company built for global impact, with search and development capabilities unconstrained by modality or geography. We identify the world’s most innovative assets and translate them into great medicines through a disciplined development approach and lead by experienced drug developers. Our focus is on high-potential first- and best-in-class assets with meaningful potential for patient impact worldwide.
About us


Our Advantages / Our Ambition
Proven legacy
30+ years track record of identifying groundbreaking technologies and developing next-generation life-saving medicines
Unmatched experience
Founding leadership team with expertise in the most innovative areas of biotechnology, capabilities across the entire drug development process and deep experience in navigating the complex regulatory landscape globally
Global reach
International footprint and broad ecosystem to source the world’s best science and efficiently advance it through cross-regional clinical trials
Latest news
View MoreContact us
Have questions about us or want to learn more?